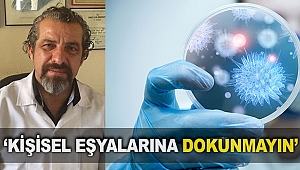
‘Kişisel eşyalarına dokunmayın’

İleri Gazete Haberleri
İleri Gazete


20 Ağustos 2020 - 14:59
Kaplumbağaları denize uğurladılar

20 Ağustos 2020 - 14:05
Rektör Özkan'ın A Takımı

20 Ağustos 2020 - 11:05
Azeri suç örgütü elebaşı Salifov, saldırıda öldürüldü

20 Ağustos 2020 - 09:32
Düden Şelalesi'nde 'kötü koku' şikayeti

19 Ağustos 2020 - 18:09
Şehit polis için mevlit

19 Ağustos 2020 - 19:08
Yakıtsız motor üretimi için destek istiyorlar

19 Ağustos 2020 - 19:54
'Türkiye'ye tatile gelin'
19 Ağustos 2020 - 17:48
‘Kişisel eşyalarına dokunmayın’

19 Ağustos 2020 - 18:45
SES kampanya başlattı

19 Ağustos 2020 - 19:41
Rektör Özkan, hasta doktor ile görüştü

19 Ağustos 2020 - 18:58
Kepez Göksu’yu güzelleştiriyor

19 Ağustos 2020 - 17:56
Patara'da konser verecekler